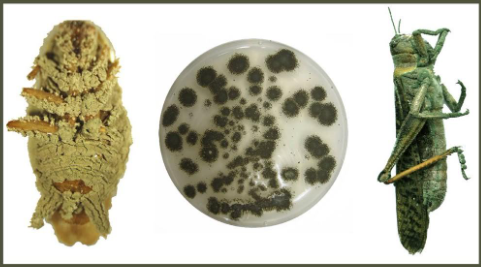
Hình 4: Nấm Metarhizium

Trong nông nghiệp, nghề trồng lúa đang mang lại nhiều giá trị kinh tế cho người dân cũng như mang lại giá trị xuất khẩu. Nghề trồng lúa từ xưa đã được ví như một kho báu của người nông dân Việt Nam, mang lại của cải, bữa cơm nuôi sống hàng ngày, mang lại công việc cho người dân. Và cho đến nay thì ngành trồng lúa vẫn không bị mai một mà còn được ngày càng phát triển mạnh mẽ, vươn tầm thế giới. Nhưng với sự phát triển mạnh mẽ này cũng đi kèm không ít những khó khăn trong trồng trọt. Bởi theo thời gian, mỗi trường thay đổi nên kéo theo nhiều loại bệnh và sâu bệnh khác nhau, xuất hiện quanh năm, xuất hiện suốt thời kỳ phát triển của lúa. Có rất nhiều loại sâu hại như bọ xít, sâu gai, sâu cuốn lá, sâu đục thân,…Và một loại sâu hại cũng ảnh hưởng không hề nhẹ tới năng suất lúa là châu chấu, cào cào. Sau đây mời bà con cùng tìm hiểu
Giới thiệu bệnh sâu hại
– Châu chấu, cào cào có tên khoa học là Oxya Chinensis, Patanga succinta, Ceracris spp. Châu chấu còn được chia ra rất nhiều loại gây hại như châu chấu hại lúa Oxya chinensis, châu chấu sống lưng vàng Patanga succinta, châu chấu tre lưng vàng Ceracris spp. Thuộc họ Acrididae thuộc bộ Orthoptera. Loài châu chấu này gây hại lên cả lá non và lá già lúa. Chúng tấn công hàng loạt và rất nhanh. Nếu như không phát hiện sớm thì chúng sẽ dễ dàng nhanh chóng phá hoại cả ruộng vườn. Loại sâu hại này thường xuất hiện quanh năm. Châu chấu (cào cào) phân bố chủ yếu ở các vùng trồng lúa và hoa màu của Việt Nam và trên Thế Giới. Cả châu chấu trưởng thành và con non đều gây hại đến cây lúa, hoa màu và gây hại trong tất cả các giai đoạn phát triển và trưởng thành của cây.

Đặc điểm hình thái
– Vòng đời châu chấu (cào cào) có thời gian khoảng 200-210 ngày.
+ Giai đoạn trứng: từ 15-21 ngày
+ Giai đoạn sâu non: 100 ngày
+ Giai đoạn trưởng thành: 3 tháng
– Trứng châu chấu có hình ống, hơi cong ở giữa, một đầu hơi to màu vàng đậm, ổ trứng hình túi, phía trong trứng sẽ xếp liền hai hàng. Trứng đẻ thành 6 ổ từ 10-15 quả trong thân lúa, nếp gấp lá lúa hay trong những cây cỏ ven ruộng.
– Châu chấu (cào cào) non thường có 6 tuổi, màu xanh, râu sợi chỉ, mảnh lưng ngực phía trước dài hơn đầu, mầm cánh kéo dài tới đốt thứ giữa bụng.
– Con cái trưởng thành thường dài hơn con đực, màu xanh vàng hoặc nâu bóng, râu đầu sợi chỉ có 23-29 đốt, mắt kép. Góc dưới phía sau mảnh lưng ở đốt bụng thứ 3 thứ 4 của con cái có dạng gai. Mép sau của mảnh sinh dục dưới có 4 răng nhọn, giữa chúng có khoảng cách bằng nhau

Đối tượng gây hại
– Châu chấu thường gây hại chủ yếu trên các loại cây hoa màu như: ngô, lúa, đậu,… Với đặc tính vốn có của chúng thì cây hoa màu chính là con mồi mà chúng nhắm đến.
Triệu chứng gây hại
– Vị trí gây hại:
+ Châu chấu (cào cào) sẽ tấn công, gặm hết cả lá non và lá già, làm khuyết từng mảng hoặc thủng lá, những lá bị nặng sẽ còn trơ lại gân lá.
– Hình dạng:
+ Chúng thường cắn, gặm từ viền mép lá vào trong tạo thành những vệt gợn sóng, hoặc những vết gặm nhấm.
– Màu sắc:
+ Thông thường châu chấu khi gây hại sẽ chỉ mất đi hình dạng ban đầu của lá, còn về màu sắc gần như không có thay đổi.
– Sự phát triển của vết bệnh:
+ Châu chấu di chuyển thành từng đàn, cả con trưởng thành và con non đều gây hại, làm khuyết từng mảng lá, hoặc thủng lá, khi lá bị hại nặng chỉ còn trơ lại gân lá. Khi di chuyển thành đàn lớn chúng gây thành dịch, có thể phá hại toàn bộ ruộng hoa màu, lúa, ngô,…
+ Châu chấu (cào cào) xuất hiện quanh năm và cũng tùy thuộc vào số lượng có thể gây tác hại lớn hay nhỏ. Chúng thường hoạt động mạnh vào thời tiết mát mẻ, thường từ 7-10 giờ sáng và 3-5 giờ chiều.

Đặc điểm sinh thái của châu chấu (cào cào)
– Con châu chấu trưởng thành thường sống 3 tháng, và con cái sống lâu hơn con đực. Sau khi hóa trưởng thành được từ 5-40 ngày thì chúng bắt đầu giao phối, sau 10-41 ngày (trung bình trên trên dưới 20 ngày) bắt đầu đẻ trứng. Mỗi con cái có thể đẻ 3 ổ, mỗi ổ sẽ có khoảng 10-102 quả. Châu chấu (cào cào) thường thích đẻ trứng ở những nơi đất ẩm, xốp, có nhiều cỏ dại, nhiều ánh nắng, thích đẻ trên đất cát pha.
– Con non ngay sau khi nở đã bắt đầu có dấu hiệu đi phá hại. Con trưởng thành thường hoạt động mạnh vào 7-10 giờ và 16-17 giờ. Ban đêm châu chấu (cào cào) thường có xu hướng bay vào những khu vực hay những bóng ánh sáng, ánh lửa sáng hoặc đèn tia tử ngoại. Khi nhảy xuống mặt nước thì chúng có thể bơi, bất kể môi trường trên cạn hay dưới nước chúng vẫn có khả năng tồn tại. Châu chấu phá hại quanh năm, đặc biệt là ở những nơi cấy sớm hoặc muộn, trái thời vụ.
Thiên địch
Sử dụng thiên địch nấm ký sinh Metarhizium có thể tiêu diệt châu chấu mà không độc hại đến môi trường, ngoài ra còn tiêu diệt được một số côn trùng khác.
Biện pháp phòng bệnh
– Biện pháp thủ công:
+ Dọn dẹp, vệ sinh, thu gom sạch cỏ ở các ruộng hoặc trên bờ ruộng
+ Theo dõi sát tình hình mật độ châu chấu (cào cào) trên lúa mùa, nếu mật độ cao thì có thể huy động người dân dùng vợt bắt trước khi vào vụ sản xuất.

+ Châu chấu (cào cào) có xu tính hướng sáng nên sẽ bay theo ánh sáng vào ban đêm. Do vậy ở những vùng có mật độ cao có thể dùng cách lấy độc trị độc, đốt ánh lửa sáng để dẫn dụ chúng đến và tiêu diệt giảm mật độ trên đồng ruộng.
– Biện pháp sinh học:
+ Sử dụng các chế phẩm sinh học Metarhizium để phòng ngừa sự phát triển mạnh của chúng, tuy nhiên hiệu quả hơi chậm. Điểm mạnh của phương pháp này là có hiệu quả lâu dài, an toàn, bảo vệ thiên địch và môi trường.
Biện pháp xử lý châu chấu
– Khi châu chấu trưởng thành đã phát sinh với mật độ cao trên diện rộng thì việc phun thuốc diệt trừ bắt buộc phải làm đồng loạt, rất tốn công sức và chi phí. Ở nhiều nơi bà con nông dân sử dụng hạt bắp xâu thành chuỗi nhúng vào dung dịch thuốc pha lẫn rỉ đường treo rải rác trong vườn để làm bả dẫn dụ tiêu diệt châu chấu hiệu quả.
– Cách tốt nhất là nên theo dõi phát hiện châu chấu non xuất hiện vào đầu mùa mưa rồi dùng thuốc có tác dụng tiếp xúc, vị độc để trừ ngay thì hiệu quả sẽ cao hơn. Diệt trừ theo phương châm: Phát hiện ổ trứng đến đâu, phun diệt trừ đến đó để giảm thiểu kinh phí. Phun trực tiếp lên ổ châu chấu đang co cụm, chớm nở ở tuổi 1, tuổi 2, nhằm đạt hiệu quả cao hơn. Bà con có thể tham khảo một số sản phẩm trừ sâu điển hình của Nghi Anh như Sumo, Chim én, Đại bàng, Lửng mật,…
Thuốc trừ sâu

